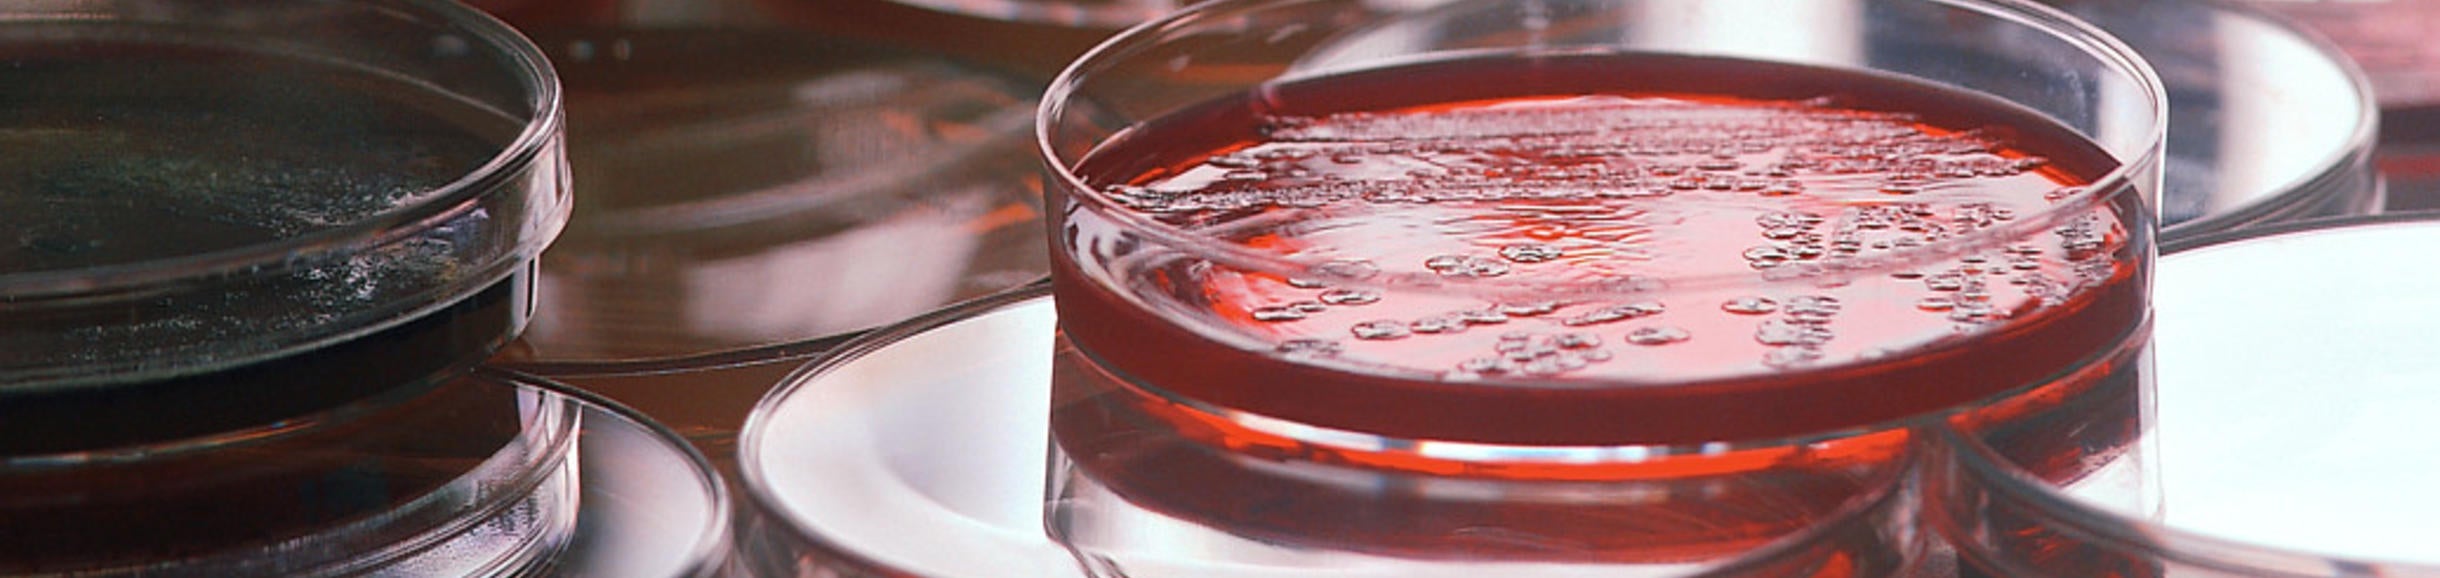
CMDB Banner

Overview
CMDB Advising
-
Change of Major Criteria for CMDB
To declare a major, students must be in good academic standing (quarter and cumulative GPAs at 2.0 and above), a Life Science Core GPA of 2.0 or higher, and no grades lower than a C- in any attempted major requirement. If upper-division courses have been taken, a minimum upper-division GPA of a 2.0 is also required. Must be able to complete the degree within 216 units. AP/IB units or transfer units earned prior to graduating high school are excluded when determining unit range for change of major criteria and 216 unit maximum. Must have letter grade for all science courses. Freshman (up to 44.9 units)
Sophomore (45 - 89.9 units)
Junior (90 - 134.9 units)
Senior (135 units & above)
Completion of...
- BIOL 005A/BIOL 05LA or BIOL 020
- CHEM 001A/CHEM 01LA
- CHEM 001B/CHEM 01LB
- MATH 006B or MATH 007A or MATH9A
Completion of all previously listed criteria and the following courses:
- BIOL 005B
- BIOL 005C
- CHEM 001C
- CHEM 01LC
- MATH 007B or MATH 009B
Completion of all previously listed criteria and completion of at least one of the following sequences:
*Note: Organic Chemistry is the preferred sequence
- CHEM 008A
- CHEM 08LA
- CHEM 008B
- CHEM 08LB
- CHEM 008C
- CHEM 08LC
- PHYS 002A
- PHYS 02LA
- PHYS 002B
- PHYS 02LB
- PHYS 002C
- PHYS 02LC
Completion of all previously listed criteria and the following courses:
- STAT 010*
- BCH 100 or both BCH 110A and BCH 110B
- BIOL 102
- GPA of 2.0 or higher in all attempted upper division courses applicable to the major
*STAT 100A was offered up until Fall 2021 and is accepted
-
Additional Information About the CMDB Major
CMDB Additional Documents
-
Course Planning Materials for CMDB
CMDB Degree Summary Sheets
CMDB Sample Four-Year Course Plans
CMDB Schedule of Course Offerings
CMDB Advisors
CNAS Professional Academic Advisors provide students with individual guidance throughout their academic careers at UCR and help them achieve realistic academic goals. Professional Academic Advisors can assist you with declaring or changing your major or minor, course repeats, the process for taking courses outside of UCR, taking a leave from UCR, and questions about withdrawing or readmitting to UCR.

CMDB Lead Faculty Advisor
A Lead Faculty Advisor is assigned for each major. Faculty advisors are available to assist students with guidance regarding graduate or professional school, opportunities to participate in research, independent study, or internships. Faculty advisors also may provide students with advice and mentoring regarding career goals.